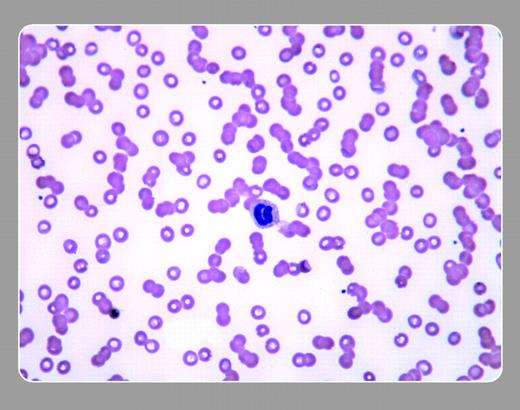
Figure 1. A 69-year-old man had lethargy and lower-back pain for several months. His physical findings showed mild congestive heart failure and no focal neurologic signs. The CBC was normal except for thrombocytopenia. Renal and hepatic function were normal. A sedimentation rate was markedly elevated, and his peripheral smear (× 40) is shown. . / The stacking of cells (rouleaux formation) facilitates the rate of red cell sedimentation, a phenomenon that may be seen on a peripheral smear. The appearance of rouleaux may be artificially caused by a poor preparation of the smear or by viewing the slide in a thickened area. When rouleaux formation is truly present, it is caused by an increase in cathodal proteins, such as immunoglobulins and fibrinogen. Although myeloma and macroglobulinemias are first considered by hematologists, other causes occur more frequently, such as acute and chronic infections, connective tissue diseases, and chronic liver disease. . / This patient also had plasma cells that were seen on the peripheral blood smear. The diagnosis was IgA myeloma (plasma cell leukemia), and it was accompanied by hyperviscosity that required plasmapheresis. . / Neil Abramson, Baptist Cancer Institute

A 69-year-old man had lethargy and lower-back pain for several months. His physical findings showed mild congestive heart failure and no focal neurologic signs. The CBC was normal except for thrombocytopenia. Renal and hepatic function were normal. A sedimentation rate was markedly elevated, and his peripheral smear (× 40) is shown.
The stacking of cells (rouleaux formation) facilitates the rate of red cell sedimentation, a phenomenon that may be seen on a peripheral smear. The appearance of rouleaux may be artificially caused by a poor preparation of the smear or by viewing the slide in a thickened area. When rouleaux formation is truly present, it is caused by an increase in cathodal proteins, such as immunoglobulins and fibrinogen. Although myeloma and macroglobulinemias are first considered by hematologists, other causes occur more frequently, such as acute and chronic infections, connective tissue diseases, and chronic liver disease.
This patient also had plasma cells that were seen on the peripheral blood smear. The diagnosis was IgA myeloma (plasma cell leukemia), and it was accompanied by hyperviscosity that required plasmapheresis.
 Neil Abramson, Baptist Cancer Institute
Neil Abramson, Baptist Cancer Institute
A 69-year-old man had lethargy and lower-back pain for several months. His physical findings showed mild congestive heart failure and no focal neurologic signs. The CBC was normal except for thrombocytopenia. Renal and hepatic function were normal. A sedimentation rate was markedly elevated, and his peripheral smear (× 40) is shown.
The stacking of cells (rouleaux formation) facilitates the rate of red cell sedimentation, a phenomenon that may be seen on a peripheral smear. The appearance of rouleaux may be artificially caused by a poor preparation of the smear or by viewing the slide in a thickened area. When rouleaux formation is truly present, it is caused by an increase in cathodal proteins, such as immunoglobulins and fibrinogen. Although myeloma and macroglobulinemias are first considered by hematologists, other causes occur more frequently, such as acute and chronic infections, connective tissue diseases, and chronic liver disease.
This patient also had plasma cells that were seen on the peripheral blood smear. The diagnosis was IgA myeloma (plasma cell leukemia), and it was accompanied by hyperviscosity that required plasmapheresis.
 Neil Abramson, Baptist Cancer Institute
Neil Abramson, Baptist Cancer Institute
Many Blood Work images are provided by the ASH IMAGE BANK, a reference and teaching tool that is continually updated with new atlas images and images of case studies. For more information or to contribute to the Image Bank, visit www.ashimagebank.org.

This feature is available to Subscribers Only
Sign In or Create an Account Close Modal